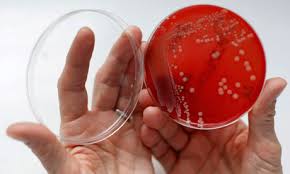

Reginald Kenneth Dwight (Londres, 25 de marzo de 1947), más conocido como Sir Elton John, CBE, es un cantante, compositor y pianista británico, de rock, glam rock y piano rock.
Se estima que ha vendido entre 200 a 250 millones de sus producciones musicales vendidas en todo el mundo,lo que lo convierte en uno de los músicos con mayores ventas de todos los tiempos.
En el año 2004 la revista Rolling Stone le otorgó el puesto 49 en su lista de los 100 mejores artistas de la historia (entendiendo la mencionada revista el término "artista" no en su sentido real -no hay un solo escritor en dicha lista, por ejemplo- sino como equivalente de músico de música ligera anglosajona desde la segunda mitad del siglo XX).
Sus múltiples reconocimientos incluyen el título de Sir luego de ser nombrado miembro de la Orden del Imperio Británico por Isabel II del Reino Unido. De acuerdo con Billboard, es el tercer artista más grande de todos los tiempos en Estados Unidos, solo por detrás de The Beatles y Madonna. También ha colaborado con el lanzamiento musical de artistas como Anastacia.
Bienvenidos al blog de ciencia para pasar el rato, siempre será mejor que ver la tele.
viernes, 31 de mayo de 2013
Julius Richard Petri o cómo crear un microuniverso en una placa de cristal
En 1877, un microbiólogo y médico alemán tuvo la genial idea de enfrentar dos discos de vidrio, que, encajados, atrapasen el suficiente oxígeno como para generar un campo de cultivo idóneo para observar el desarrollo de las bacteria. Así nacieron los cristales más útiles de los laboratorios, las placas de Petri
Julius Richard Petri es el responsable de que hoy el hombre pueda llegar a ser testigo, por ejemplo, de cómo nace un pollo de un huevo. Médico y microbiólogo, este alemán, que nació un día como hoy hace 161 años, ideó un método -más bien un medio- para poder estudiar el comportamiento de los microorganismos: las populares placas que llevan su nombre, las placas Petri, los cristales más útiles de los laboratorios. Hasta 1877 resultaba casi imposible establecer un campo de cultivo de bacterias que permitiese una óptima observación de su comportamiento. Los microorganismos se cultivaban en un caldo líquido y acababan, inevitablemente, contaminados e inservibles, y los pocos avances en este campo caminaban hacia métodos engorrosos y difíciles de llevar a cabo que nunca revelaban nada claro.
A Julius Richard Petri se le ocurrió entonces enfrentar dos discos de vidrio, uno un poco más grande que el otro, y formar una caja que, sin que su cierre fuese hermético, permitiese entrar el oxígeno. Ideó el médico alemán un mecanismo circular -hoy convertido en todo un imprescindible en todos los laboratorios del mundo-, que adoptó su apellido y ha pasado a la historia como placa de Petri. También se le conoce como cápsula de Petri o caja de Petri.
Durante un siglo, los recurridos discos de Julius Richard Petrihan permitido observar y analizar el universo de las bacterias, sobre todo las animales y las humanas, y han resultado especilamente importantes para, tras estudiar el comportamiento de las células y conocer cómo se reproducen, dar con las vacunas de enfermedades contagiosas que durante muchos años fueron mortales.
Además del inventor de las placas de Petri, Julius Richard Petri fue el asistente de laboratorio del Premio Nobel de Medicina Robert Koch, un hombre que le abrió las puertas de la bacteriología y junto al que Julius Richard Petri desarrolló su pasión por este campo de la ciencia. Todo un referente en del desarrollo metodológico para la práctica microbiológica y descubridor del bacilo de la tuberculosis, Koch ya había intentado encontrar sin mucho éxito un medio sólido sobre el que estudiar el universo microscópico. Probó con placas de gelatina colocadas en frascos de vidrio, pero no funcionó. Entonces, Julius Richard Petri, inspirándose en la idea de su mentor, vertió agar fundido -una sustancia gelatinosa que se obtiene de algas marinas- en el fondo de un plato para luego cubrirlo con una tapa fácilmente extraíble.
Hasta la popularización del invento de Julius Richard Petri, los pocos estudios que se llevaban a cabo en medios sólidos se hacían siguiendo el primitivo sistema de Koch, la gelatina se extendía en un costado de un tubo de ensayo, pero la obtención de colonias separadas resultaba casi imposible y la visibilidad hacia el interior era escasa y engorrosa. Julius Richard Petri se puso manos a la obra para encontrar una solución. Diseñó una placa de aproximadamente diez centímetros de diámetro con bordes de 1 a 1,5 centímetros de alto. Soportaba su plato de 0,5 a 0,7 centímetros de espesor y estaba cubierto con una tapa redondeada, un poco más grande que la base, lo que la permitía cerrarla sin que llegase a crearse una cápsula hermética, dando lugar a una campo de cultivo idóneo -y con oxígeno- en el que podían separarse las colonias por dilución de la muestra.
Permitía además el invento de Julius Richard Petri observar toda la superficie sin necesidad de levantar la tapa y analizar así el comportamiento de los microorganismos. En el caso de bacterias y levaduras, la cápsula de Julius Richard Petridebía colocarse -y sigue haciéndose así- apoyada en la incubadora sobre la tapa -es decir, boca abajo- para que la gelatina quedase en la parte superior y, al condensarse el vapor de agua generado por el metabolismo microbiano, cayese sobre la cubierta. De esta forma, se evitaba que los microorganismos se disgregasen y continuasen formando colonias independientes.

¿Es el 3D una amenaza a la placa de Petri?
El gran despegue de la bacteriología y, sobre todo, de la biología molecular no hubiese sido posible sin la aportación de Julius Richard Petri, todavía fundamental para la comunidad científica más de un siglo después. Pero el inevitable desarrollo ha llevado a un grupo de científicos a sumergirse en la experimentación de técnicas de cultivo en tres dimensiones obteniendo interesantes resultados que podría relegar a un segundo plano a las populares placas de Petri.
Su elevado coste y poca aceptación hace que, de momento, las técnicas en 3D sean solo un proceso en pruebas frente al que se prefiere el material ideado por Julius Richard Petri, pero sus grandes defensores destacan el potencial de este método, que permite contemplar comportamientos de las células ocultos en las dos dimensiones. Aseguran que, a diferencia del plato de Julius Richard Petri, la tercera dimensión aporta una idea más cercana del comportamiento celular en vivo y los biólogos expertos en el cáncer han contemplado, a través de técnicas tridimensionales, cómo las células cambian entre estados malignos y no malignos.
Julius Richard Petri, un peculiar hombre de rígida disciplina militar
Nacido en Barmen, Alemania, en 1852, Julius Richard Petri, microbiólogo y médico, hombre corpulento, fiel a una rígida disciplina militar en todos los aspectos de su vida, fue director del sanatorio antituberculoso de Göbersdorf, dirigió el Museo de la Higiene en Berlín y se jubiló tras pasar unos años al frente de la Oficina Imperial de Salud. Sus placas pasaron a ser un elemento imprescindible en cada laboratorio, parte del conocido como «material de vidrio», pero no consiguieron catapultar el nombre del alemán a los puestos destacados de la historia de la ciencia. Tampoco lo hicieron sus otros grandes descubrimientos, un filtro de arena para bacterias y, más relacionada con sus placas Petri, una técnica para la clonación de las cepas bacterianas en cultivos inclinados de agar formadas en tubos de ensayo.

Julius Richard Petri fue, sin embargo, el responsable del meteórico desarrollo de la microbiología a finales del siglo XVI. Gracias a sus placas pudieron aislarse la mayor parte de las bacterias responsables de entonces mortales enfermedades como la tuberculosis, la difteria o el cólera y publicó casi 150 artículos relacionados con la higiene y la bacteriología.
Julius Richard Petri es el responsable de que hoy el hombre pueda llegar a ser testigo, por ejemplo, de cómo nace un pollo de un huevo. Médico y microbiólogo, este alemán, que nació un día como hoy hace 161 años, ideó un método -más bien un medio- para poder estudiar el comportamiento de los microorganismos: las populares placas que llevan su nombre, las placas Petri, los cristales más útiles de los laboratorios. Hasta 1877 resultaba casi imposible establecer un campo de cultivo de bacterias que permitiese una óptima observación de su comportamiento. Los microorganismos se cultivaban en un caldo líquido y acababan, inevitablemente, contaminados e inservibles, y los pocos avances en este campo caminaban hacia métodos engorrosos y difíciles de llevar a cabo que nunca revelaban nada claro.
A Julius Richard Petri se le ocurrió entonces enfrentar dos discos de vidrio, uno un poco más grande que el otro, y formar una caja que, sin que su cierre fuese hermético, permitiese entrar el oxígeno. Ideó el médico alemán un mecanismo circular -hoy convertido en todo un imprescindible en todos los laboratorios del mundo-, que adoptó su apellido y ha pasado a la historia como placa de Petri. También se le conoce como cápsula de Petri o caja de Petri.
Durante un siglo, los recurridos discos de Julius Richard Petrihan permitido observar y analizar el universo de las bacterias, sobre todo las animales y las humanas, y han resultado especilamente importantes para, tras estudiar el comportamiento de las células y conocer cómo se reproducen, dar con las vacunas de enfermedades contagiosas que durante muchos años fueron mortales.
Además del inventor de las placas de Petri, Julius Richard Petri fue el asistente de laboratorio del Premio Nobel de Medicina Robert Koch, un hombre que le abrió las puertas de la bacteriología y junto al que Julius Richard Petri desarrolló su pasión por este campo de la ciencia. Todo un referente en del desarrollo metodológico para la práctica microbiológica y descubridor del bacilo de la tuberculosis, Koch ya había intentado encontrar sin mucho éxito un medio sólido sobre el que estudiar el universo microscópico. Probó con placas de gelatina colocadas en frascos de vidrio, pero no funcionó. Entonces, Julius Richard Petri, inspirándose en la idea de su mentor, vertió agar fundido -una sustancia gelatinosa que se obtiene de algas marinas- en el fondo de un plato para luego cubrirlo con una tapa fácilmente extraíble.
Hasta la popularización del invento de Julius Richard Petri, los pocos estudios que se llevaban a cabo en medios sólidos se hacían siguiendo el primitivo sistema de Koch, la gelatina se extendía en un costado de un tubo de ensayo, pero la obtención de colonias separadas resultaba casi imposible y la visibilidad hacia el interior era escasa y engorrosa. Julius Richard Petri se puso manos a la obra para encontrar una solución. Diseñó una placa de aproximadamente diez centímetros de diámetro con bordes de 1 a 1,5 centímetros de alto. Soportaba su plato de 0,5 a 0,7 centímetros de espesor y estaba cubierto con una tapa redondeada, un poco más grande que la base, lo que la permitía cerrarla sin que llegase a crearse una cápsula hermética, dando lugar a una campo de cultivo idóneo -y con oxígeno- en el que podían separarse las colonias por dilución de la muestra.
Permitía además el invento de Julius Richard Petri observar toda la superficie sin necesidad de levantar la tapa y analizar así el comportamiento de los microorganismos. En el caso de bacterias y levaduras, la cápsula de Julius Richard Petridebía colocarse -y sigue haciéndose así- apoyada en la incubadora sobre la tapa -es decir, boca abajo- para que la gelatina quedase en la parte superior y, al condensarse el vapor de agua generado por el metabolismo microbiano, cayese sobre la cubierta. De esta forma, se evitaba que los microorganismos se disgregasen y continuasen formando colonias independientes.

¿Es el 3D una amenaza a la placa de Petri?
El gran despegue de la bacteriología y, sobre todo, de la biología molecular no hubiese sido posible sin la aportación de Julius Richard Petri, todavía fundamental para la comunidad científica más de un siglo después. Pero el inevitable desarrollo ha llevado a un grupo de científicos a sumergirse en la experimentación de técnicas de cultivo en tres dimensiones obteniendo interesantes resultados que podría relegar a un segundo plano a las populares placas de Petri.
Su elevado coste y poca aceptación hace que, de momento, las técnicas en 3D sean solo un proceso en pruebas frente al que se prefiere el material ideado por Julius Richard Petri, pero sus grandes defensores destacan el potencial de este método, que permite contemplar comportamientos de las células ocultos en las dos dimensiones. Aseguran que, a diferencia del plato de Julius Richard Petri, la tercera dimensión aporta una idea más cercana del comportamiento celular en vivo y los biólogos expertos en el cáncer han contemplado, a través de técnicas tridimensionales, cómo las células cambian entre estados malignos y no malignos.
Julius Richard Petri, un peculiar hombre de rígida disciplina militar
Nacido en Barmen, Alemania, en 1852, Julius Richard Petri, microbiólogo y médico, hombre corpulento, fiel a una rígida disciplina militar en todos los aspectos de su vida, fue director del sanatorio antituberculoso de Göbersdorf, dirigió el Museo de la Higiene en Berlín y se jubiló tras pasar unos años al frente de la Oficina Imperial de Salud. Sus placas pasaron a ser un elemento imprescindible en cada laboratorio, parte del conocido como «material de vidrio», pero no consiguieron catapultar el nombre del alemán a los puestos destacados de la historia de la ciencia. Tampoco lo hicieron sus otros grandes descubrimientos, un filtro de arena para bacterias y, más relacionada con sus placas Petri, una técnica para la clonación de las cepas bacterianas en cultivos inclinados de agar formadas en tubos de ensayo.

Julius Richard Petri fue, sin embargo, el responsable del meteórico desarrollo de la microbiología a finales del siglo XVI. Gracias a sus placas pudieron aislarse la mayor parte de las bacterias responsables de entonces mortales enfermedades como la tuberculosis, la difteria o el cólera y publicó casi 150 artículos relacionados con la higiene y la bacteriología.
jueves, 30 de mayo de 2013
Las misteriosas "Flores de Hielo"
Las superficies heladas de los mares árticos y antárticos en ocasiones nos ofrecen hermosos e inusuales espectáculos, como los cautivadores 'campos' de 'flores de hielo', cuya belleza además podría explicarnos el origen de la vida en la Tierra.
Estas obras de arte de la naturaleza, que pueden llegar a ocupar vastas extensiones de hielo marino, se forman a partir de los vapores de agua que se escapan de las fisuras y huecos de la capa de hielo superficial y que, al entrar en contacto con el aire frío, se congelan.
La sal de la superficie se cristaliza y sirve de núcleo para la formación de la 'flor', según explica el blog Curiosón. A partir de este proceso de 'nucleación', que ocurre a temperaturas próximas a los 22 grados bajo cero, las estructuras de las flores crecen verticalmente a medida que el aire húmedo va entrando en contacto con la escarcha recién formada. Estas formaciones pueden encontrarse tanto en los mares del Ártico como de la Antártida, e incluso en lagos de agua dulce, siempre que la temperatura sea lo suficientemente baja, dicen los investigadores.
El graduado Jeff Bowman y su profesora Jody Deming, de la Universidad de Washington, sacaron preciosas fotografías de este fenómeno cuando realizaban un trabajo de investigación oceanográfica en aguas del océano Ártico, ya que alrededor del barco rompehielos que los trasladaba se formaban 'flores'.

Además de lo espectaculares que resultan, estas formaciones se convierten en un laboratorio ideal para estudiar los microorganismos que habitan en estas regiones y, según los investigadores de la Universidad de Washington, podrían ayudar a descubrir a dónde vamos o de dónde venimos, ya que estas flores también producen sustancias químicas, como formaldehídos, que pueden dar pistas sobre el origen de la vida en la Tierra, así como sobre la presencia de vida en otros planetas.
Estas obras de arte de la naturaleza, que pueden llegar a ocupar vastas extensiones de hielo marino, se forman a partir de los vapores de agua que se escapan de las fisuras y huecos de la capa de hielo superficial y que, al entrar en contacto con el aire frío, se congelan.
La sal de la superficie se cristaliza y sirve de núcleo para la formación de la 'flor', según explica el blog Curiosón. A partir de este proceso de 'nucleación', que ocurre a temperaturas próximas a los 22 grados bajo cero, las estructuras de las flores crecen verticalmente a medida que el aire húmedo va entrando en contacto con la escarcha recién formada. Estas formaciones pueden encontrarse tanto en los mares del Ártico como de la Antártida, e incluso en lagos de agua dulce, siempre que la temperatura sea lo suficientemente baja, dicen los investigadores.
El graduado Jeff Bowman y su profesora Jody Deming, de la Universidad de Washington, sacaron preciosas fotografías de este fenómeno cuando realizaban un trabajo de investigación oceanográfica en aguas del océano Ártico, ya que alrededor del barco rompehielos que los trasladaba se formaban 'flores'.

Además de lo espectaculares que resultan, estas formaciones se convierten en un laboratorio ideal para estudiar los microorganismos que habitan en estas regiones y, según los investigadores de la Universidad de Washington, podrían ayudar a descubrir a dónde vamos o de dónde venimos, ya que estas flores también producen sustancias químicas, como formaldehídos, que pueden dar pistas sobre el origen de la vida en la Tierra, así como sobre la presencia de vida en otros planetas.
UNA ESPONJA DE MAR CONTRA EL CÁNCER DE MAMA
La noticia de que Angelina Jolie se sometió a una doble mastectomía con el fin de reducir las posibilidades de desarrollar un cáncer, debido a sus antecedentes familiares, nos da pie para recordar lo último en tratamientos médicos contra este mal.
Así como esta noticia ha sido desplegada en todos los medios de comunicación del mundo, hace algunos meses, una pequeña esponja de mar apareció en los titulares de miles de periódicos del planeta.
Se trataba de la eribulina, un nuevo y eficaz medicamento contra el cáncer de mama, obtenido de una esponja de mar (Halichondria okadai), que es tóxica y muy frecuente en la costa japonesa del Pacífico.

Este fármaco, afirman sus creadores, puede mejorar en un 20% (unos dos meses) la esperanza de vida de las mujeres ya tratadas previamente y que padecen metástasis.
Así como esta noticia ha sido desplegada en todos los medios de comunicación del mundo, hace algunos meses, una pequeña esponja de mar apareció en los titulares de miles de periódicos del planeta.
Se trataba de la eribulina, un nuevo y eficaz medicamento contra el cáncer de mama, obtenido de una esponja de mar (Halichondria okadai), que es tóxica y muy frecuente en la costa japonesa del Pacífico.

Este fármaco, afirman sus creadores, puede mejorar en un 20% (unos dos meses) la esperanza de vida de las mujeres ya tratadas previamente y que padecen metástasis.
domingo, 26 de mayo de 2013
Células madre y tejidos y órganos de repuesto
El reciente anuncio por parte del equipo de Kathrin Plath y William Lowry de la Universidad de California de que han conseguido obtener células de piel adulta humana para convertirlas en células madre embrionarias, unido a los resultados similares obtenidos por los equipos de James Thomson en EEUU y Shinya Yamanaka en Japón, parecen confirmar que este método funciona y es reproducible, lo que supone un importante avance en la investigación en este campo.
Las células madre son, por decirlo así, como los comodines del cuerpo humano, ya que son capaces de convertirse en cualquier otro tipo de célula, y hasta ahora la forma más sencilla de obtenerlas era extraerlas de embriones, donde son muy abundantes, lo que tiene toda la lógica del mundo, ya que el ser humano completo con todos sus órganos y tejidos diferentes que nace al cabo de los nueve meses de gestación tiene su origen en una sola célula, el cigoto.

Célula madre no diferenciada
El problema de esto es que para muchos es inmoral utilizar los embriones de esta manera porque extraer esas células supone su destrucción, aunque hay anunciados resultados que afirman que es posible extraer una célula de un embrión de ocho semanas sin que este sufra ningún problema en su desarrollo y obtener un cultivo de células madre a partir de esta célula extraída.
Así, por ejemplo en los Estados Unidos no se puede investigar en este campo con fondos federales, y en la propia Unión Europea la situación varía casi de país a país, y mientras que en España las cosas han ido avanzando en los últimos años, Alemania aún está planteándose suavizar sus leyes al respecto ante el temor expresado por sus científicos de estar quedándose atrás en este campo.
La importancia de las investigaciones con este tipo de células reside en que se piensa que podrían abrir nuevas vías en el tratamiento de enfermedades que van desde la diabetes (Células madre permiten a diabéticos brasileños abandonar la insulina) a la enfermedad de Parkinson (Neuronas de células madre embrionarias frenan el Parkinson en monos) al permitir obtener células de reemplazo para otras dañadas, y también podrían abrir posibilidades increíbles en el campo de los transplantes, ya que podrían servir para cultivar tejidos, y eventualmente órganos, de repuesto para los pacientes que ya no se trataría de que fueran compatibles con su sistema inmune, sino que serían tejidos y órganos de su propio cuerpo.
En esto último, que suena a ciencia ficción, ha habido un par de avances muy interesantes en las últimas semanas.
Por un lado, en Finlandia, a un paciente al que habían tenido que extirparle la mandíbula superior por culpa de un tumor, le pudieron «fabricar» una nueva a partir de células madre extraídas de sus propios tejidos grasos que fueron luego cultivadas en un laboratorio: Finnish patient gets new jaw from own stem cells.
Del cultivo se extrajeron células madre mesenquimales, que son capaces de convertirse en células musculares, de vasos sanguíneos, o de huesos, células que luego fueron implantadas en su propio abdomen junto con una especie de andamio orgánico construido en fosfato de calcio, donde se les dejó crecer durante nueve meses.
Cuando lo extrajeron, el «andamio» estaba rodeado de varios tipos de tejido e incluso de vasos sanguíneos, y una vez implantado en la cabeza del paciente, sujeto en su sitio con tornillos, y conectado a los vasos sanguíneos circundantes usando microcirugía para asegurar su conservación, el paciente ya puede volver a hablar y comer sin necesidad de la prótesis que utilizaba antes.
El otro avance, es la fabricación de un corazón de rata en el laboratorio por parte de científicos de la Universidad de Minnesota, proceso que pudieron llevar a cabo utilizando la estructura inerte de un corazón extraído de una rata muerta en el que tras extraer todas sus células consiguieron hacer crecer tejido cardíaco nuevo a partir de una «papilla» de células de corazón de ratas recién nacidas, papilla rica en células madre y células progenitoras, que son similares a las primeras pero menos flexibles en cuanto a en qué tejidos se pueden convertir.

Corazón de rata antes, durante y después del proceso de eliminación de células / Thomas Matthiesen
Obviamente las diferencias entre ratas y humanos son considerables, y aún falta mucho que investigar, pero cuando la doctora Dorys Taylor, que dirige el equipo que creó estos corazones, estuvo en España recientemente, justamente presentando estos resultados, vaticinó que habrá corazones nuevos en cinco años, y siempre sin problemas de rechazo ya que se utilizarían células madre del propio paciente para generar el corazón nuevo.
En este mismo campo, otra noticia reciente de interés es la técnica desarrollada por el equipo de la investigadora María Blasco, del Centro Nacional de Investigaciones Oncológicas (CNIO) y recientemente presentada, que permite teñir secciones de tejido de forma selectiva, de tal modo que las células madre pueden detectarse a simple vista.

Sección de piel con células madre en rojo / Flores et al
El método de Flores y su equipo se basa en el hecho de que las células madre tienen los telómeros, las secciones de los extremos de sus cromosomas, más largos que otros tipos de células, lo que permite que un marcador fluorescente desarrollado por el equipo para adherirse precisamente a los telómeros haga destacar más estas células que las otras, ya que el marcador tiene más sitio al que agarrarse.
Así, las células madre salen en rojo una vez procesada la imagen, las intermedias en amarillo, y las más viejas en verde.
Para terminar, creo conveniente recordar que todos estos avances están todavía en estado muy experimental, así que aún faltan años para que se puedan aplicar de manera cotidiana, pero ciertamente la impresión es que los avances en este campo se producen a pasos cada vez más agigantados.
Las células madre son, por decirlo así, como los comodines del cuerpo humano, ya que son capaces de convertirse en cualquier otro tipo de célula, y hasta ahora la forma más sencilla de obtenerlas era extraerlas de embriones, donde son muy abundantes, lo que tiene toda la lógica del mundo, ya que el ser humano completo con todos sus órganos y tejidos diferentes que nace al cabo de los nueve meses de gestación tiene su origen en una sola célula, el cigoto.

Célula madre no diferenciada
El problema de esto es que para muchos es inmoral utilizar los embriones de esta manera porque extraer esas células supone su destrucción, aunque hay anunciados resultados que afirman que es posible extraer una célula de un embrión de ocho semanas sin que este sufra ningún problema en su desarrollo y obtener un cultivo de células madre a partir de esta célula extraída.
Así, por ejemplo en los Estados Unidos no se puede investigar en este campo con fondos federales, y en la propia Unión Europea la situación varía casi de país a país, y mientras que en España las cosas han ido avanzando en los últimos años, Alemania aún está planteándose suavizar sus leyes al respecto ante el temor expresado por sus científicos de estar quedándose atrás en este campo.
La importancia de las investigaciones con este tipo de células reside en que se piensa que podrían abrir nuevas vías en el tratamiento de enfermedades que van desde la diabetes (Células madre permiten a diabéticos brasileños abandonar la insulina) a la enfermedad de Parkinson (Neuronas de células madre embrionarias frenan el Parkinson en monos) al permitir obtener células de reemplazo para otras dañadas, y también podrían abrir posibilidades increíbles en el campo de los transplantes, ya que podrían servir para cultivar tejidos, y eventualmente órganos, de repuesto para los pacientes que ya no se trataría de que fueran compatibles con su sistema inmune, sino que serían tejidos y órganos de su propio cuerpo.
En esto último, que suena a ciencia ficción, ha habido un par de avances muy interesantes en las últimas semanas.
Por un lado, en Finlandia, a un paciente al que habían tenido que extirparle la mandíbula superior por culpa de un tumor, le pudieron «fabricar» una nueva a partir de células madre extraídas de sus propios tejidos grasos que fueron luego cultivadas en un laboratorio: Finnish patient gets new jaw from own stem cells.
Del cultivo se extrajeron células madre mesenquimales, que son capaces de convertirse en células musculares, de vasos sanguíneos, o de huesos, células que luego fueron implantadas en su propio abdomen junto con una especie de andamio orgánico construido en fosfato de calcio, donde se les dejó crecer durante nueve meses.
Cuando lo extrajeron, el «andamio» estaba rodeado de varios tipos de tejido e incluso de vasos sanguíneos, y una vez implantado en la cabeza del paciente, sujeto en su sitio con tornillos, y conectado a los vasos sanguíneos circundantes usando microcirugía para asegurar su conservación, el paciente ya puede volver a hablar y comer sin necesidad de la prótesis que utilizaba antes.
El otro avance, es la fabricación de un corazón de rata en el laboratorio por parte de científicos de la Universidad de Minnesota, proceso que pudieron llevar a cabo utilizando la estructura inerte de un corazón extraído de una rata muerta en el que tras extraer todas sus células consiguieron hacer crecer tejido cardíaco nuevo a partir de una «papilla» de células de corazón de ratas recién nacidas, papilla rica en células madre y células progenitoras, que son similares a las primeras pero menos flexibles en cuanto a en qué tejidos se pueden convertir.

Corazón de rata antes, durante y después del proceso de eliminación de células / Thomas Matthiesen
Obviamente las diferencias entre ratas y humanos son considerables, y aún falta mucho que investigar, pero cuando la doctora Dorys Taylor, que dirige el equipo que creó estos corazones, estuvo en España recientemente, justamente presentando estos resultados, vaticinó que habrá corazones nuevos en cinco años, y siempre sin problemas de rechazo ya que se utilizarían células madre del propio paciente para generar el corazón nuevo.
En este mismo campo, otra noticia reciente de interés es la técnica desarrollada por el equipo de la investigadora María Blasco, del Centro Nacional de Investigaciones Oncológicas (CNIO) y recientemente presentada, que permite teñir secciones de tejido de forma selectiva, de tal modo que las células madre pueden detectarse a simple vista.

Sección de piel con células madre en rojo / Flores et al
El método de Flores y su equipo se basa en el hecho de que las células madre tienen los telómeros, las secciones de los extremos de sus cromosomas, más largos que otros tipos de células, lo que permite que un marcador fluorescente desarrollado por el equipo para adherirse precisamente a los telómeros haga destacar más estas células que las otras, ya que el marcador tiene más sitio al que agarrarse.
Así, las células madre salen en rojo una vez procesada la imagen, las intermedias en amarillo, y las más viejas en verde.
Para terminar, creo conveniente recordar que todos estos avances están todavía en estado muy experimental, así que aún faltan años para que se puedan aplicar de manera cotidiana, pero ciertamente la impresión es que los avances en este campo se producen a pasos cada vez más agigantados.
sábado, 25 de mayo de 2013
Los ingenieros copian a la naturaleza
La naturaleza ofrece interesantes modelos para mejorar los materiales de construcción. El pico de un tucán, las escamas del pez vaca o la concha de una oreja de mar tienen en común su ligereza a la vez que su gran resistencia y dureza, características que los ingenieros aún no han logrado imitar en el diseño de nuevos materiales.
La ciencia de materiales, que se ocupa de estudiar la relación entre su estructura y sus propiedades, ha vuelto sus ojos a hacia los “biomateriales”, es decir, lo que la naturaleza utiliza para dar forma a sus logrados diseños, según explica en la revista Science Marc André Meyers, del departamento de Ingeniería Mecánica, Aeroespacial y Ciencia de los Materiales de la Universidad de California.
Los materiales que constituyen a los seres vivos, desde los que forman el hueso a los integran el ala que soporta el vuelo de las aves, tienen una serie de características comunes que los distinguen de los que los humanos utilizamos en nuestras construcciones. En primer lugar, la capacidad para autoensamblarse de abajo arriba. En segundo lugar, su multifuncionalidad. Muchos componentes de los seres vivos se utilizan con diversos fines. Un ejemplo, las plumas sirven para volar, como camuflaje y para mantener la temperatura de las aves. Lo huesos sirven como andamiaje al organismo, están implicados en la formación de los glóbulos rojos y protegen a los órganos internos.
Además, a diferencia de lo que ocurre con los materiales sintéticos empleados en diversas construcciones, la mayoría de los biomateriales se sintetizan a temperatura y presión ambiente y en un medio acuoso (el del interior del organismo). Y lo que es muy importante, estos materiales naturales han surgido como solución a las demandas que la plantea la existencia de los organismos, por lo que su eficacia está ampliamente probada. A esto hay que unir la capacidad de regeneración en muchos casos, a diferencia de los sintéticos, que sufren deterioros irreversibles.

Resistente y flexible
Entre los materiales utilizados en la naturaleza, quizá uno de los más conocidos sea la tela de las arañas. Fabricada con seda, es capaz de resistir grandes fuerzas de estiramiento sin romperse, como muy bien saben la mayoría de los insectos que, como un proyectil, chocan contra ellas en pleno vuelo. Sus posibilidades de escapar una vez que han caído en la telaraña son escasas, porque, además, se quedan pegados. Y es que la seda que fabrican las arañas “es más fuerte que casi cualquier material“, como explica Meyers.
Pero no es el único ejemplo que los ingenieros estudian con meticulosidad para obtener nuevos materiales. Aquí te presentamos otros menos conocidos. Duro y ligero
Duro y ligero
El pico del tucán podría servir de inspiración para el diseño de aviones ultraligeros y componentes de vehículos.Constituye un tercio de la longitud del ave y debe ser bastante grueso para permitir las actividades de forrajeo (recolección de comida) y construcción del nido en lo alto del árbol, aunque sin tener un peso excesivo. La estructura del pico del tucán es bastante elaborada, con una carcasa externa queratinosa y una estructura celular ósea interna.
La solución para satisfacer todas esas demandas ambientales es una ingeniosa estrategia que le dota de dureza con poco peso. El interior del pico del es una especie de “espuma” rígida hecha de fibras óseas y membranas parecidas a las del tímpano intercaladas entre capas de queratina, la proteína que compone cuernos, pelo y uñas.
Una característica distintiva adicional del pico del Tucán es un núcleo hueco dentro de esa espuma, con lo que disminuye el peso. El resultado es una sólida “espuma” constituida por células herméticas que dan una rigidez adicional al pico. Finalmente, la espuma está cubierta con azulejos de queratina, cada uno de aproximadamente 50 micrómetros de diámetro y 1 micrómetro de espesor, que se pegan para producir una superficie continua, como las tejas de un tejado.
La oreja de mar

Este molusco guarda el secreto de cómo amortiguar los golpes y podría servir de inspiración para fabricar chalecos antibala o materiales cerámicos mucho más resistentes. La concha de la oreja de mar es capaz de desviar las grietas de rotura y frenarlas. Lo logra superponiendo capas de materiales o interfaces para obstaculizar la fractura. Una concha de oreja de mar se compone de miles de capas de “azulejos” de carbonato de calcio (más conocido como tiza), aproximadamente 10 micrómetros de profundidad y 0,5 micrómetros de espesor -la centésima parte del espesor de un cabello humano. Las pilas irregulares de azulejos finos refractan la luz para producir el brillo característico de nácar y también impiden la rotura de la concha, ya que se organizan en una estructura altamente ordenada dispuesta en de la forma que les confiere la mayor dureza teóricamente posible.
El pez vaca

El pez vaca, que puede encontrarse en aguas tropicales y subtropicales en los océanos atlánticos y Pacífico ofrece un buen ejemplo de material ligero y resistente a la vez. Su caparazón está compuesto deescamas mineralizadas que no se superponen sino que se ligan por un sistema parecido a una cremallera. Las escamas se alojan en una cama de fibras que da flexibilidad al caparazón del pez. El resultado, un caparazón con una resistencia a la fractura muy superior a la de su principal constituyente, el carbonato cálcico.
El velcro, inspirado en una planta

El velcro inspirado en una planta. Unas semillas pegadas al pantalón del ingeniero suizo George de Mestral, que paseaba a su perro, y la dificultad para eliminarlas culminaron en el velcro, que utilizamos ampliamente y que hace la vida más fácil a todos aquellos que odian atarse los cordones de los zapatos. El cardo Xanthium spinosum, comúnmente conocido como arrancamoños, tiene unas semillas con ganchos curvados especialmente preparadas para “viajar” prendidas en el pelo o ropa de quienes se ponen a su alcance. Inspirado en estas semillas, el ingeniero ideó un sistema de cierre con dos cintas: una con pequeñas púas flexibles que acaban en forma de gancho, como la semilla del arrancamoños, y otra que cubierta de fibras enmarañadas que forman bucles. Ambas cintas, como las semillas tienen a engancharse con facilidad.
La ciencia de materiales, que se ocupa de estudiar la relación entre su estructura y sus propiedades, ha vuelto sus ojos a hacia los “biomateriales”, es decir, lo que la naturaleza utiliza para dar forma a sus logrados diseños, según explica en la revista Science Marc André Meyers, del departamento de Ingeniería Mecánica, Aeroespacial y Ciencia de los Materiales de la Universidad de California.
Los materiales que constituyen a los seres vivos, desde los que forman el hueso a los integran el ala que soporta el vuelo de las aves, tienen una serie de características comunes que los distinguen de los que los humanos utilizamos en nuestras construcciones. En primer lugar, la capacidad para autoensamblarse de abajo arriba. En segundo lugar, su multifuncionalidad. Muchos componentes de los seres vivos se utilizan con diversos fines. Un ejemplo, las plumas sirven para volar, como camuflaje y para mantener la temperatura de las aves. Lo huesos sirven como andamiaje al organismo, están implicados en la formación de los glóbulos rojos y protegen a los órganos internos.
Además, a diferencia de lo que ocurre con los materiales sintéticos empleados en diversas construcciones, la mayoría de los biomateriales se sintetizan a temperatura y presión ambiente y en un medio acuoso (el del interior del organismo). Y lo que es muy importante, estos materiales naturales han surgido como solución a las demandas que la plantea la existencia de los organismos, por lo que su eficacia está ampliamente probada. A esto hay que unir la capacidad de regeneración en muchos casos, a diferencia de los sintéticos, que sufren deterioros irreversibles.

Resistente y flexible
Entre los materiales utilizados en la naturaleza, quizá uno de los más conocidos sea la tela de las arañas. Fabricada con seda, es capaz de resistir grandes fuerzas de estiramiento sin romperse, como muy bien saben la mayoría de los insectos que, como un proyectil, chocan contra ellas en pleno vuelo. Sus posibilidades de escapar una vez que han caído en la telaraña son escasas, porque, además, se quedan pegados. Y es que la seda que fabrican las arañas “es más fuerte que casi cualquier material“, como explica Meyers.
Pero no es el único ejemplo que los ingenieros estudian con meticulosidad para obtener nuevos materiales. Aquí te presentamos otros menos conocidos.
 Duro y ligero
Duro y ligeroEl pico del tucán podría servir de inspiración para el diseño de aviones ultraligeros y componentes de vehículos.Constituye un tercio de la longitud del ave y debe ser bastante grueso para permitir las actividades de forrajeo (recolección de comida) y construcción del nido en lo alto del árbol, aunque sin tener un peso excesivo. La estructura del pico del tucán es bastante elaborada, con una carcasa externa queratinosa y una estructura celular ósea interna.
La solución para satisfacer todas esas demandas ambientales es una ingeniosa estrategia que le dota de dureza con poco peso. El interior del pico del es una especie de “espuma” rígida hecha de fibras óseas y membranas parecidas a las del tímpano intercaladas entre capas de queratina, la proteína que compone cuernos, pelo y uñas.
Una característica distintiva adicional del pico del Tucán es un núcleo hueco dentro de esa espuma, con lo que disminuye el peso. El resultado es una sólida “espuma” constituida por células herméticas que dan una rigidez adicional al pico. Finalmente, la espuma está cubierta con azulejos de queratina, cada uno de aproximadamente 50 micrómetros de diámetro y 1 micrómetro de espesor, que se pegan para producir una superficie continua, como las tejas de un tejado.
La oreja de mar

Este molusco guarda el secreto de cómo amortiguar los golpes y podría servir de inspiración para fabricar chalecos antibala o materiales cerámicos mucho más resistentes. La concha de la oreja de mar es capaz de desviar las grietas de rotura y frenarlas. Lo logra superponiendo capas de materiales o interfaces para obstaculizar la fractura. Una concha de oreja de mar se compone de miles de capas de “azulejos” de carbonato de calcio (más conocido como tiza), aproximadamente 10 micrómetros de profundidad y 0,5 micrómetros de espesor -la centésima parte del espesor de un cabello humano. Las pilas irregulares de azulejos finos refractan la luz para producir el brillo característico de nácar y también impiden la rotura de la concha, ya que se organizan en una estructura altamente ordenada dispuesta en de la forma que les confiere la mayor dureza teóricamente posible.
El pez vaca

El pez vaca, que puede encontrarse en aguas tropicales y subtropicales en los océanos atlánticos y Pacífico ofrece un buen ejemplo de material ligero y resistente a la vez. Su caparazón está compuesto deescamas mineralizadas que no se superponen sino que se ligan por un sistema parecido a una cremallera. Las escamas se alojan en una cama de fibras que da flexibilidad al caparazón del pez. El resultado, un caparazón con una resistencia a la fractura muy superior a la de su principal constituyente, el carbonato cálcico.
El velcro, inspirado en una planta

El velcro inspirado en una planta. Unas semillas pegadas al pantalón del ingeniero suizo George de Mestral, que paseaba a su perro, y la dificultad para eliminarlas culminaron en el velcro, que utilizamos ampliamente y que hace la vida más fácil a todos aquellos que odian atarse los cordones de los zapatos. El cardo Xanthium spinosum, comúnmente conocido como arrancamoños, tiene unas semillas con ganchos curvados especialmente preparadas para “viajar” prendidas en el pelo o ropa de quienes se ponen a su alcance. Inspirado en estas semillas, el ingeniero ideó un sistema de cierre con dos cintas: una con pequeñas púas flexibles que acaban en forma de gancho, como la semilla del arrancamoños, y otra que cubierta de fibras enmarañadas que forman bucles. Ambas cintas, como las semillas tienen a engancharse con facilidad.
lunes, 20 de mayo de 2013
España
Continuando visitando el mundo, vamos a la madre patria.
Te invito a que conozcas cada ciudad, son fotografías espectaculares!!!
España
Te invito a que conozcas cada ciudad, son fotografías espectaculares!!!
España
sábado, 18 de mayo de 2013
Helio
El helio es uno de los gases nobles de la tabla periódica de los elementos.
Su número atómico es dos (Z=2), esto nos indica que tiene dos protones y además que un átomo neutro de helio tendrá dos electrones.
Su número másico es cuatro (A=4), esto nos indica que tiene cuatro subpartículas con masa en el núcleo y si restamos A-Z calculamos su número de neutrones 4-2=2.
Sus dos electrones se encuentran moviéndose en la corteza, alrededor del núcleo.
Isótopos
En la atmósfera terrestre podemos encontrar isótopos de helio estables como el Helio tres y el Helio cuatro. El isótopo de helio, de número másico A=4, es un millón de veces más abundante que el de número másico A=3.
Características del helio
El helio es un gas inerte, no es combustible, no reacciona con otros elementos.
Es incoloro, inodoro, no se congela, no pasa a líquido fácilmente.
El helio es muy ligero.
Su ligereza ha sido utilizada para rellenar globos y zepelines.
El globo de helio más famoso es el que utilizó Felix Baumgartner para realizar su salto estratosférico.
El helio puede ser muy risible, si aspiras este gas y emites sonidos comprobarás que tu voz cambia.
La velocidad del sonido en el helio es tres veces mayor que en el aire.
La velocidad del sonido en el helio es tres veces mayor que en el aire.
(Velocidad del sonido en el aire = 340 m/s)
Si se inhala helio, cambia la voz, se hace más aguda, aflautada, como la de un pato. Las cuerdas vocales cambian la frecuencia de su vibración cuando el helio las atraviesa.
¡Ojo! porque inhalar helio puede ser peligroso ya que este gas desplaza al oxígeno que necesitamos para una respiración normal.
Si se inhala helio, cambia la voz, se hace más aguda, aflautada, como la de un pato. Las cuerdas vocales cambian la frecuencia de su vibración cuando el helio las atraviesa.
¡Ojo! porque inhalar helio puede ser peligroso ya que este gas desplaza al oxígeno que necesitamos para una respiración normal.
El helio se utiliza en Resonancia magnética nuclear aplicada a la medicina, en las naves espaciales, en los equipos de submarinismo, como refrigerante...
Precisamente hace unos dias la ESA (European Space Agency) ha anunciado que su observatorio espacial Herschel ha agotado todo el helio líquido de su sistema de refrigeración.
Al comenzar la misión hace más de tres años, el depósito del satélite tenía más de 2 300 litros de helio.
Su evaporación programada era fundamental para mantener los instrumentos con una temperatura de cero absoluto.
El pasado 30 de Abril se registró una subida de temperatura del instrumental que avisó que el helio se había agotado.
miércoles, 15 de mayo de 2013
Daft Punk - Derezzed (from TRON: Legacy)
Daft Punk es un dúo de música electrónica formado por los músicos franceses Guy Manuel de Homem-Christo (nacido el 8 de febrero de 1974) y Thomas Bangalter (nacido el 3 de enero de 1975).
Daft Punk alcanzó una gran popularidad en el estilo house a finales de la década de los '90, en Francia y continuó con su éxito los años siguientes, usando el estilo synthpop.
El dúo también es acreditado por la producción de canciones que se consideran esenciales en el estilo french house. Ellos fueron representados desde 1996 hasta el 2008 por Pedro Winter (Busy P) el jefe de Ed Banger Records.
A principios de la carrera del grupo, los miembros de la banda estaban influidos por bandas como The Beach Boys y The Rolling Stones. Bangalter y de Homem-Christo se encontraban originalmente en una banda llamada Darlin', que se disolvió después de un corto período de tiempo, dejando a los dos experimentar con música por su cuenta.
El dúo se convirtió en Daft Punk, y lanzaron su aclamado álbum debut Homework en 1997. El segundo álbum, Discovery, lanzado en el 2001, fue aún más exitoso, impulsado por los sencillos «One More Time», «Digital Love» y «Harder, Better, Faster, Stronger». En marzo de 2005, el dúo lanzó el álbum Human After All, recibiendo críticas mixtas. Sin embargo, «Robot Rock» y «Technologic» tuvieron éxito en el Reino Unido.
Daft Punk hizo una gira a lo largo del 2006 y 2007 y lanzó su álbum en vivo Alive 2007, el cuál ganó un Grammy por Mejor Álbum de Electrónica/Dance. El dúo compuso la música para la película Tron: Legacy y en el 2010 lanzó el álbum de la banda sonora de la película.
Daft Punk es conocido por sus conciertos excéntricos, en los que elementos y efectos visuales se incorporan con la música. El dúo también es conocido por su énfasis en sus componentes visuales y de su historia, así como el uso de trajes adornados de robot mientras aparecen en público y mientras se presentan. Actualmente ocupa el puesto #44 en la encuesta realizada en 2012 por la revista DJmag, bajando 16 puestos con respecto al año anterior.
Daft Punk alcanzó una gran popularidad en el estilo house a finales de la década de los '90, en Francia y continuó con su éxito los años siguientes, usando el estilo synthpop.
El dúo también es acreditado por la producción de canciones que se consideran esenciales en el estilo french house. Ellos fueron representados desde 1996 hasta el 2008 por Pedro Winter (Busy P) el jefe de Ed Banger Records.
A principios de la carrera del grupo, los miembros de la banda estaban influidos por bandas como The Beach Boys y The Rolling Stones. Bangalter y de Homem-Christo se encontraban originalmente en una banda llamada Darlin', que se disolvió después de un corto período de tiempo, dejando a los dos experimentar con música por su cuenta.
El dúo se convirtió en Daft Punk, y lanzaron su aclamado álbum debut Homework en 1997. El segundo álbum, Discovery, lanzado en el 2001, fue aún más exitoso, impulsado por los sencillos «One More Time», «Digital Love» y «Harder, Better, Faster, Stronger». En marzo de 2005, el dúo lanzó el álbum Human After All, recibiendo críticas mixtas. Sin embargo, «Robot Rock» y «Technologic» tuvieron éxito en el Reino Unido.
Daft Punk hizo una gira a lo largo del 2006 y 2007 y lanzó su álbum en vivo Alive 2007, el cuál ganó un Grammy por Mejor Álbum de Electrónica/Dance. El dúo compuso la música para la película Tron: Legacy y en el 2010 lanzó el álbum de la banda sonora de la película.
Daft Punk es conocido por sus conciertos excéntricos, en los que elementos y efectos visuales se incorporan con la música. El dúo también es conocido por su énfasis en sus componentes visuales y de su historia, así como el uso de trajes adornados de robot mientras aparecen en público y mientras se presentan. Actualmente ocupa el puesto #44 en la encuesta realizada en 2012 por la revista DJmag, bajando 16 puestos con respecto al año anterior.
martes, 14 de mayo de 2013
Para tu cerebro la música es tan importante como el sexo

Nuestro cerebro nos recompensa cuando tenemos comportamientos necesarios para la supervivencia, como la comida o el sexo, con esa droga natural que es la dopamina. Y aunque pareciera un exceso aquello de que la vida sin música es un error, un nuevo estudio reveló que de hecho escuchar nuestra música favorita activa zonas del cerebro comunmente asociadas con la recompensa sexual.
Científicos de la Universidad McGill en Montreal midieron con resonancia magnética las ondas cerebrales de los participantes, quienes debían escuchar 60 fragmentos de música que no conocían, seleccionada en un programa similar a iTunes a partir de sus gustos previamente declarados. La resonancia mostró que el núcleo accumbens (una zona asociada con el reconocimiento de patrones complejos, predicción de reacciones, y sobre todo en la asignación de valor emocional y de recompensa a los estímulos) interactúa en sesiones placenteras de escucha con el cortex auditivo, el área que almacena información sobre los sonidos y la música que hemos escuchado.
Dependiendo qué tanto le gustara el fragmento musical escuchado, la persona le asignaba un valor en una subasta hipotética. La doctora Valorie Salimpoor afirmó que “cuando la gente escucha una pieza musical que nunca han escuchado antes, la actividad en una región del cerebro puede predecir de manera confiable y consistente si les gustará y si la comprarían; este es el núcleo accumbens, que está implicado en la formación de expectativas que pueden generar la sensación de recompensa.”
“Lo que hace a la música tan poderosa emocionalmente”, continúa Salimpoor, “es la creación de expectativas. La actividad en el núcleo accumbens es indicador de que se alcanzaron o sobrepasaron las expectativas, y en nuestro estudio encontramos que mientras más actividad observáramos en esta zona del cerebro mientras la gente escuchaba música, con más probabilidad estarían dispuestos a comprarla.”

En otras palabras, el cerebro asigna valor a la música a través de la dopamina, lo que refuerza el comportamiento y nos hace querer escuchar más. Esta es la misma ruta a través de la cuál nos enseña lo que es importante para nosotros a nivel emocional e incluso en términos de supervivencia, como comer o tener sexo.
La clase de mañana
Hoy en el universo,
Psicologia
lunes, 6 de mayo de 2013
Los beneficios de la combinación de la Canela y la Miel
Canela y miel son las únicas substancias alimenticias en el planeta que no se echan a perder ni se pudren. Aunque su contenido se puede convertir en azucares, de todas formas la miel siempre es miel y en conjunto con la canela pueden curar muchas enfermedades.
Algunos tips:
Si la miel se deja por largos períodos de tiempo en un lugar oscuro se cristalizara, cuando esto pase abra la tapa y con el calor de agua hervida, déjela derretirse. La miel estará tan buena como cuando nueva.
Nunca hierva la miel ni la ponga en el microondas, de esta manera se matan sus enzimas.
La miel es producida por la mayoría de los países del mundo, la ciencia la acepta como un medio muy efectivo para tratar enfermedades. Puede ser utilizada sin dar efectos secundarios y tomada en la dosis correcta, aunque sea dulce, no afecta a los diabéticos.
‘Weekly World News’. Una revista en Canadá (17.01.1995) produjo una lista de enfermedades que pueden ser curadas con miel y canela:
Enfermedades del Corazón
Haga una pasta de miel y canela, aplique todas las mañanas en pan, en vez de mermelada y cómala regularmente como parte del desayuno. Esto reducirá el colesterol en las arterias y prevendrá en el paciente ataques al corazón. Además, aquellos que ya hayan pasado por un ataque al corazón, si siguen este proceso, estarán protegidos de sufrir un siguiente ataque al corazón. El uso regular de estas substancias ayuda a retener el aliento sano y a fortalecer el músculo y el movimiento rítmico del corazón.
En Estados Unidos y Canadá, varios asilos de ancianos han curado pacientes con mucho éxito pacientes que cuyas venas han perdido flexibilidad y se han tapado. La miel y la canela las revitalizan.
Artritis
Pacientes con artritis pueden tomar diariamente por las mañanas y las noches una taza de agua caliente con dos cucharadas de miel y una cucharada pequeña de canela en polvo. Si se toma regularmente incluso la artritis crónica puede ser curada. Recientes investigaciones por la Universidad de Copenhagen demostraron que aquellos doctores que trataron a sus pacientes con una mezcla de una cucharada de miel y media cucharadita de canela antes del desayuno, corroboraron que en una semana, de 200 pacientes, 73 ya no sentían dolores artríticos y al mes, casi todos los pacientes que no podian ni caminar o moverse por los dolores, se movían sin sentir dolores.
Digestión
La canela esparcida en dos cucharadas de miel tomadas antes de las comidas pueden reducir la acidez y digerir hasta los alimentos mas pesados.
Catarros y Resfríes
Un científico en España ha comprobado que la miel contiene un ingrediente natural que mata los gérmenes de la influenza y que protege a los pacientes del catarro.
Longevidad
El te hecho con miel y canela, tomado regularmente disminuye los daños causados por la edad avanzada en los tejidos. Tome cuatro cucharadas de miel, una de canela en polvo y tres tazas de agua hirviendo para hacer un te. Tome un cuarto de taza, tres a cuatro veces al dia. Mantiene a la piel fresca y disminuye los daños causados por el envejecimiento de tejidos y radicales libres, alargando el periodo de vitalidad regularmente a mas de 100 años.
Infecciones de la Vejiga
Tome dos cucharaditas de canela en polvo y una cucharada sopera de miel en un vaso de agua tibia y bebalo normalmente. Destruirá los gérmenes en la vejiga
Colesterol
Dos cucharadas miel y tres cucharaditas de canela en polvo mezcladas con 16 onzas de te administrados a un paciente con altos niveles de colesterol, redujeron sus niveles en la sangre un 10 por ciento en las primeras dos horas del tratamiento. Como mencionado anteriormente para pacientes artríticos, si tomado tres veces al día, cualquier enfermedad de colesterol crónica es curada. De acuerdo a la información en esta revista, la miel pura tomada como alimento a diario ayuda a reducir el colesterol.
Resfriados
Aquellos que sufren de severo resfrio pueden tomar una cucharada de miel tibia con 1/4 de cucharadita de canela por espacio de tres días. Este proceso cura cualquier resfrío y aclara la sinusitis.
Estómago
Miel tomada con canela también ayuda a curar el estomago, aclara y hasta cura ulceras completamente.
Gases
Estudios hechos en India y Japón revelan que la miel y la canela reducen el gas en el sistema digestivo.
Sistema Inmunológico
El uso diario de miel y canela en polvo fortifica al sistema inmunológico y protege al cuerpo de bacterias y virus. Científicos han encontrado en la miel varias vitaminas e hierro en grandes cantidades.
El uso constante de la miel fortifica las células blancas de la sangre y protege de enfermedades.
Espinillas
Tres cucharadas de miel y una de canela en polvo, haciendo una pasta, se puede aplicar a espinillas antes de dormir, lavándose al siguiente día con agua tibia. Si se realiza por dos semanas, desaparecerá espinillas
desde la raíz.
Infecciones de la Piel
La aplicación de miel y canela en partes iguales en las partes afectadas curan el eczema y todo tipo de infecciones de la piel.
Perdida de Peso
En las mañanas, media hora antes del desayuno y antes de ir a dormir, beber una taza de agua previamente hervida con miel y canela. Si se bebe regularmente, reduce el peso de hasta la persona más obesa. También, el beber la mezcla regularmente no permite a las grasas acumularse en el cuerpo aun si la persona lleva una dieta alta en calorías.
Cáncer
Recientes estudios en Japón y Australia han demostrado que canceres avanzados de estomago y huesos han sido totalmente curados. Pacientes sufriendo de estos canceres deberán tomar diariamente una cuchara de miel y una de canela por espacio de un mes tres veces al día.
Fatiga
Estudios han comprobado que el contenido de azúcar en la miel ayuda y no debilita la cantidad de fuerza en el cuerpo. Personas de la tercera edad que toman miel y canela en partes iguales, están más alertas y son mas flexibles.
El Dr. Milton, que ha hecho la investigación, dice que un vaso con una cucharada de miel y espolvoreado de canela todos los días al levantarse y a las tres de la tarde, cuando la vitalidad del cuerpo empieza a disminuir, incrementa la vitalidad del cuerpo en el espacio de solo una semana.
Halitosis, (Mal Aliento)
Personas en Suramérica suelen hacer gárgaras con una cucharada de miel y canela en agua caliente, conservando el aliento fresco por todo el día.
Perdida del Sentido del Oído
A diario, miel con canela en partes iguales ayuda a reparar tejido dañado de los oídos. Que no recuerda en su niñez haber comido pan tostado con mantequilla y canela..
Si usted desea compartir esta información con amigos, seres queridos y compañeros hágalo. Todos necesitamos ayuda y buena salud. Lo que hagan de esta información ya es responsabilidad de cada quien.
Fuente: Saiku
Algunos tips:
Si la miel se deja por largos períodos de tiempo en un lugar oscuro se cristalizara, cuando esto pase abra la tapa y con el calor de agua hervida, déjela derretirse. La miel estará tan buena como cuando nueva.
Nunca hierva la miel ni la ponga en el microondas, de esta manera se matan sus enzimas.
La miel es producida por la mayoría de los países del mundo, la ciencia la acepta como un medio muy efectivo para tratar enfermedades. Puede ser utilizada sin dar efectos secundarios y tomada en la dosis correcta, aunque sea dulce, no afecta a los diabéticos.
‘Weekly World News’. Una revista en Canadá (17.01.1995) produjo una lista de enfermedades que pueden ser curadas con miel y canela:
Enfermedades del Corazón
Haga una pasta de miel y canela, aplique todas las mañanas en pan, en vez de mermelada y cómala regularmente como parte del desayuno. Esto reducirá el colesterol en las arterias y prevendrá en el paciente ataques al corazón. Además, aquellos que ya hayan pasado por un ataque al corazón, si siguen este proceso, estarán protegidos de sufrir un siguiente ataque al corazón. El uso regular de estas substancias ayuda a retener el aliento sano y a fortalecer el músculo y el movimiento rítmico del corazón.
En Estados Unidos y Canadá, varios asilos de ancianos han curado pacientes con mucho éxito pacientes que cuyas venas han perdido flexibilidad y se han tapado. La miel y la canela las revitalizan.
Artritis
Pacientes con artritis pueden tomar diariamente por las mañanas y las noches una taza de agua caliente con dos cucharadas de miel y una cucharada pequeña de canela en polvo. Si se toma regularmente incluso la artritis crónica puede ser curada. Recientes investigaciones por la Universidad de Copenhagen demostraron que aquellos doctores que trataron a sus pacientes con una mezcla de una cucharada de miel y media cucharadita de canela antes del desayuno, corroboraron que en una semana, de 200 pacientes, 73 ya no sentían dolores artríticos y al mes, casi todos los pacientes que no podian ni caminar o moverse por los dolores, se movían sin sentir dolores.
Digestión
La canela esparcida en dos cucharadas de miel tomadas antes de las comidas pueden reducir la acidez y digerir hasta los alimentos mas pesados.
Catarros y Resfríes
Un científico en España ha comprobado que la miel contiene un ingrediente natural que mata los gérmenes de la influenza y que protege a los pacientes del catarro.
Longevidad
El te hecho con miel y canela, tomado regularmente disminuye los daños causados por la edad avanzada en los tejidos. Tome cuatro cucharadas de miel, una de canela en polvo y tres tazas de agua hirviendo para hacer un te. Tome un cuarto de taza, tres a cuatro veces al dia. Mantiene a la piel fresca y disminuye los daños causados por el envejecimiento de tejidos y radicales libres, alargando el periodo de vitalidad regularmente a mas de 100 años.
Infecciones de la Vejiga
Tome dos cucharaditas de canela en polvo y una cucharada sopera de miel en un vaso de agua tibia y bebalo normalmente. Destruirá los gérmenes en la vejiga
Colesterol
Dos cucharadas miel y tres cucharaditas de canela en polvo mezcladas con 16 onzas de te administrados a un paciente con altos niveles de colesterol, redujeron sus niveles en la sangre un 10 por ciento en las primeras dos horas del tratamiento. Como mencionado anteriormente para pacientes artríticos, si tomado tres veces al día, cualquier enfermedad de colesterol crónica es curada. De acuerdo a la información en esta revista, la miel pura tomada como alimento a diario ayuda a reducir el colesterol.
Resfriados
Aquellos que sufren de severo resfrio pueden tomar una cucharada de miel tibia con 1/4 de cucharadita de canela por espacio de tres días. Este proceso cura cualquier resfrío y aclara la sinusitis.
Estómago
Miel tomada con canela también ayuda a curar el estomago, aclara y hasta cura ulceras completamente.
Gases
Estudios hechos en India y Japón revelan que la miel y la canela reducen el gas en el sistema digestivo.
Sistema Inmunológico
El uso diario de miel y canela en polvo fortifica al sistema inmunológico y protege al cuerpo de bacterias y virus. Científicos han encontrado en la miel varias vitaminas e hierro en grandes cantidades.
El uso constante de la miel fortifica las células blancas de la sangre y protege de enfermedades.
Espinillas
Tres cucharadas de miel y una de canela en polvo, haciendo una pasta, se puede aplicar a espinillas antes de dormir, lavándose al siguiente día con agua tibia. Si se realiza por dos semanas, desaparecerá espinillas
desde la raíz.
Infecciones de la Piel
La aplicación de miel y canela en partes iguales en las partes afectadas curan el eczema y todo tipo de infecciones de la piel.
Perdida de Peso
En las mañanas, media hora antes del desayuno y antes de ir a dormir, beber una taza de agua previamente hervida con miel y canela. Si se bebe regularmente, reduce el peso de hasta la persona más obesa. También, el beber la mezcla regularmente no permite a las grasas acumularse en el cuerpo aun si la persona lleva una dieta alta en calorías.
Cáncer
Recientes estudios en Japón y Australia han demostrado que canceres avanzados de estomago y huesos han sido totalmente curados. Pacientes sufriendo de estos canceres deberán tomar diariamente una cuchara de miel y una de canela por espacio de un mes tres veces al día.
Fatiga
Estudios han comprobado que el contenido de azúcar en la miel ayuda y no debilita la cantidad de fuerza en el cuerpo. Personas de la tercera edad que toman miel y canela en partes iguales, están más alertas y son mas flexibles.
El Dr. Milton, que ha hecho la investigación, dice que un vaso con una cucharada de miel y espolvoreado de canela todos los días al levantarse y a las tres de la tarde, cuando la vitalidad del cuerpo empieza a disminuir, incrementa la vitalidad del cuerpo en el espacio de solo una semana.
Halitosis, (Mal Aliento)
Personas en Suramérica suelen hacer gárgaras con una cucharada de miel y canela en agua caliente, conservando el aliento fresco por todo el día.
Perdida del Sentido del Oído
A diario, miel con canela en partes iguales ayuda a reparar tejido dañado de los oídos. Que no recuerda en su niñez haber comido pan tostado con mantequilla y canela..
Si usted desea compartir esta información con amigos, seres queridos y compañeros hágalo. Todos necesitamos ayuda y buena salud. Lo que hagan de esta información ya es responsabilidad de cada quien.
Fuente: Saiku
viernes, 3 de mayo de 2013
Bogavante
Come mucha cal, para formar su caparazón
El bogavante es un gran crustáceo que ocupa un lugar importante en la industria pesquera. Existen varias especies, la mayoría de las cuales son de tamaño reducido; algunas sin embargo, alcanzan dimensiones muy importantes.
El bogavante de Norteamérica es, probablemente, el mayor de todos: se pescó un ejemplar en las costas de New Bruswick de 12.3 kg.
El bogavante vive en los fondos marinos cubiertos de algas y se desplaza gracias a sus larga patas ambulatorias y a sus patas cortas natatorias situadas bajo el abdomen. La cola, muy ensanchada, le sirve de timón y de órgano impulsor cuando nada. Es de naturaleza reposada y se desplaza lentamente. Únicamente se apresura cuando se siente en peligro y, perseguido, llega a desarrollar unan velocidad apreciable en cortas distancias.
Cuando pasa el peligro, vuelve de nuevo a su vida tranquila.
Esencialmente carnívoro, el bogavante se alimenta de toda clase de criaturas marinas, y prefiere sobre todo la carroña. A veces se convierte en caníbal y devora sin vergüenza alguna a un congénere de menor tamaño.
1353712176218.jpg) El bogavante come también vegetales, cuyos tallos corta en pequeños trocitos más fáciles de ingerir. Amasa, a veces, reservas de alimentos y entierra cadáveres de peces en la arena, para sacarlos de vez en cuando y roer parte de ellos. El bogavante aumenta su tamaño por mudas sucesiva, en el curso de las cuales abandona su caparazón para fabricar uno nuevo algo más grande que el anterior. Teniendo en cuenta sus dimensiones, sus necesidades de cal son enormes.
El bogavante come también vegetales, cuyos tallos corta en pequeños trocitos más fáciles de ingerir. Amasa, a veces, reservas de alimentos y entierra cadáveres de peces en la arena, para sacarlos de vez en cuando y roer parte de ellos. El bogavante aumenta su tamaño por mudas sucesiva, en el curso de las cuales abandona su caparazón para fabricar uno nuevo algo más grande que el anterior. Teniendo en cuenta sus dimensiones, sus necesidades de cal son enormes.
Grupo: Artrópodos
Clase: Crustáceos
Orden: Decápodos
Familia: Homáridos
Género y especie: Homarius vulgaris (Bogavante)
El bogavante es un gran crustáceo que ocupa un lugar importante en la industria pesquera. Existen varias especies, la mayoría de las cuales son de tamaño reducido; algunas sin embargo, alcanzan dimensiones muy importantes.
El bogavante de Norteamérica es, probablemente, el mayor de todos: se pescó un ejemplar en las costas de New Bruswick de 12.3 kg.
El bogavante vive en los fondos marinos cubiertos de algas y se desplaza gracias a sus larga patas ambulatorias y a sus patas cortas natatorias situadas bajo el abdomen. La cola, muy ensanchada, le sirve de timón y de órgano impulsor cuando nada. Es de naturaleza reposada y se desplaza lentamente. Únicamente se apresura cuando se siente en peligro y, perseguido, llega a desarrollar unan velocidad apreciable en cortas distancias.
Cuando pasa el peligro, vuelve de nuevo a su vida tranquila.
Esencialmente carnívoro, el bogavante se alimenta de toda clase de criaturas marinas, y prefiere sobre todo la carroña. A veces se convierte en caníbal y devora sin vergüenza alguna a un congénere de menor tamaño.
1353712176218.jpg) El bogavante come también vegetales, cuyos tallos corta en pequeños trocitos más fáciles de ingerir. Amasa, a veces, reservas de alimentos y entierra cadáveres de peces en la arena, para sacarlos de vez en cuando y roer parte de ellos. El bogavante aumenta su tamaño por mudas sucesiva, en el curso de las cuales abandona su caparazón para fabricar uno nuevo algo más grande que el anterior. Teniendo en cuenta sus dimensiones, sus necesidades de cal son enormes.
El bogavante come también vegetales, cuyos tallos corta en pequeños trocitos más fáciles de ingerir. Amasa, a veces, reservas de alimentos y entierra cadáveres de peces en la arena, para sacarlos de vez en cuando y roer parte de ellos. El bogavante aumenta su tamaño por mudas sucesiva, en el curso de las cuales abandona su caparazón para fabricar uno nuevo algo más grande que el anterior. Teniendo en cuenta sus dimensiones, sus necesidades de cal son enormes.Grupo: Artrópodos
Clase: Crustáceos
Orden: Decápodos
Familia: Homáridos
Género y especie: Homarius vulgaris (Bogavante)
Suscribirse a:
Entradas (Atom)















